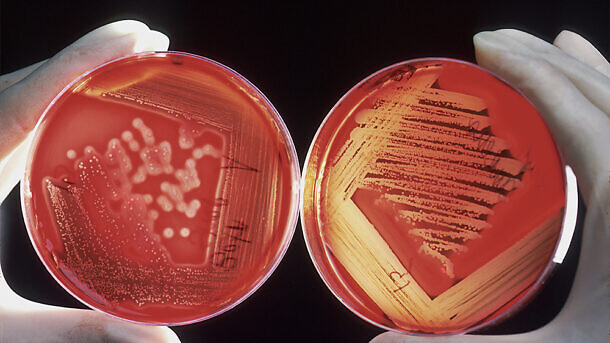

פוספומיצין נתגלה עוד ב-1969 אבל לאחרונה פרץ מחדש לאור המצאות בקטריות עם עמידות נרחבת לאנטיביוטיות בעיקר בארה”ב. המכניזם הייחודי של פעולתו, היכולת הבקטריוצידית, פעילות רחבת טווח, ופרופיל בטיחות גבוה גרמו להבנה כי זוהי אנטיביוטיקה שבהחלט כדאי להשתמש בה.
ד”ר שחף שיבר – מנהלת המחלקה לרפואה דחופה, מנהלת היחידה לאשפוז ביתי, בית החולים בילינסון.
פוספומיצין כולל שלוש טבעות של epoxide עם קשר מימן – פוספור ישיר שמקושר לחמצן אשר נמצא בתוך הקומפלקס האורגנו פוספורי. מבנה זה גורם לייחודיות של התרופה ומבדיל אותה משאר האנטיביוטיקות.
למרות שטיפול בפוספומיצין תוך ורידי בשימוש כבר 50 שנה באירופה, עדיין לא התפתחה אליה עמידות ברוב החיידקים. בנוסף, יש לאנטיביוטיקה זו פעילות סינרגיסטית עם אנטיביוטיקות שפועלות גם על קרום התא כמו בטא לקטם(דפטומיצין). הסינרגיזם הזה יכול לשמש כטיפול לזיהומים קשים לחיידקים מסוג גרם פלוס עם עמידות נרחבת וגם לחיידקים לגרם מינוס.
הפורמולציה התוך-ורידית (IV) של פוספומיצין סוקרה ונבחנה מחדש בארצות הברית ועבודה זו מאחדת ומציגה ראיות עכשוויות (מחקרים שפורסמו בין 2000 ותחילת 2019) בציפייה להתפתחות זו.
פוספומיצין IV מספק אפשרות נוספת לשיקול בניהול זיהומים MDR. המבנה הייחודי שלה יאפשר התקדמות לעידן אפוקסיד מבטיח במאבק נגד חיידקי MDR.
מנגנון פעולה
לפוספומיצין פעילות בקטריוצידית , על ידי עיכוב לא הפיך של אנזים האחראי בשלב הראשון ליצירה של פפטידוגליקאן על פני דופן תא החיידק.
פוספומיצין גורם לירידה בהצמדות החיידק לאפיתל השתן ודרכי נשימה באופן ספציפי, מדכא את הרצפטורים המאקטבים טסיות באפיתל של דרכי הנשימה שהם הרצפטורים דרכו נקשרים החיידקים פנואמוקוק והמופילוס אינפלאונזה, שהרבה פעמים מאוקטבים עקב מחלה ויראלית (RSV).
בחיידקים גרם בצילים שליליים, פוספומיצין אקטיבי כנגד רוב האנטרובקטריוצאה כולל אי קולי, קלבסיאלה, אנטרובקטר, ציטרובקטר, סרטיה, סלמנולה, שיגלה ופרוטאוס מירבליס.
בקרב החיידקים הבטא -לקטמאז גרם שלילי, לפוספומיצין יש פעילות כנגד ESBL –אי קולי וקלבסיאלה פנאומוניה. לפוספומיצין יש גם פעילות כנגד ליסטריה, ניסריה גונראה והליקובטר פילורי.
אפקטיביות קלינית לבקטריות גרם פלוס – MRSA ופנאומוקוק – תוארה יעילות ארדיקציה של סטאף אאורוס בשילוב פוספומיצין עם דפטומיצין IN VITRO. ישנה סינרגיה עם אנטביוטיקות רבות גם נגד MSSA וגם כנגד MRSA.
עמידות לפוספומיצין נמצאה ב: Staphylococcus capitis, Staphylococcus saprophyticus, species Acinetobacter, Pseudomonas species ,Stenotrophomonas maltophilia ,Burkholderia cepacia Mycobacterium tuberculosis ,Bacteroides species Morganella morganii.
פרמקוקינטיקה ופרמקודינמיקה
פוספומיצין IV נבדק במחקרי פאזה 1 ו- 2 בעשורים האחרונים, התרופה עוברת פירוק כמעט מוחלט בכליות. אין מטבוליטים פעילים לתרופה זו . 70% מהפירוק קורה במהלך 6-12 שעות הראשונות במתנדבים בריאים.
לפוספומיצין פעילות בקטריוצידית על ידי עיכוב סינטזה של ממברנת תא החיידק. לא ברור האם האינדקס הפרמקודינמי הינו בקורלציה עם ארדיקצית הבקטריה. ולכן AUC/MIC הינה המדד הפרמקודינמי היעיל ביותר.
לפוספומיצין יש אפקט פוסט אנטיביוטי(PAE) ארוך וזה קורה כאשר יש דיכוי מתמשך של גדילת בקטריה גם בהעדר ריכוז תקין אנטיביוטי או ריכוז סב-אנטיביוטי. אפקט זה תלוי אורגניזם.
תכונה זאת מאפשרת לרשום פוספומיצין בתדירות יותר נמוכה וגם לשלב זאת עם אנטיביוטיקות אחרות בעלי פעילות דומה למשל לינזוליד.
פוספומיצין בשילוב עם אנטיביוטיקות אחרות
הטיפול בפוספומיצין מצוין לשילוב עם תרופות אחרות בגלל מכנזים הפעולה הייחודי לו .
לינזוליד בקומבינציה עם פוספומיצין גם הוא הוכיח יעלות נגד MSSA ו- MRSA IN VITRO וגם ב- Galleria mellonella models. טיפול משולב הינו אופציה מצוינת לארדיקציה של בקטריות עם טווח עמידות נרחב.
בנוסף, יעילות טובה של פוספומיצין ודפטומיצין תוארו במקרה של Staphylococcus aureus עמיד לדפטומיצין. מתן של פוספומיצין IV כל 6 שעות יחד עם דפטומיצן במינון גבוה במשך חודשיים יחד עם הוצאת גוף זר הובילו להחלמה מלאה מבקטרמיה ואוסטאומיאליטיס.
נתוני יעילות קלינית
מחקר פרוספקטיבי תצפיתי עקב אחר 20 יחידות לטיפול נמרץ בגרמניה ובאוסטריה ומצא שפוספומיצין יחד עם אנטיביוטיקות נוספות יעיל בטיפול בבקטריות עם עמידות נרחבת (MDR) בחולים מורכבים וקשים. המכניזם הבקטריוצידי של האנטיביוטיקה ופעילות רחבת טווח קיימים גם בטיפול IV וגם פומי. לתרופה יש פרופיל תופעות לוואי טוב, מה שגורם לפוספומיצין להוות אנטיביוטיקה אטרקטיבית לשימוש.
במחקר שבדק יעילות של פוספומיצין נגד ESBL אי קולי , פאזה 3, מחקר רנדומלי פרוספקטיבי noninferiority, נבדקו 465 חולים שטופלו עם פוספומיצין IV או טזוצין לדלקת בדרכי השתן ופיאלונפריטיס 8. פוספומיצין נמצא יעיל באותה מידה כמן טזוצין וכן בקומפוזיט של ריפוי קליני ומיקרוביולוגי (ארדיקציה). במחקר 73% מחיידקים היו אי קולי וכ- 42% מהם היו ESBL – עם עמידות נרחבת לביטא לקטם. כאמור ריפוי קלני היה דומה בין בשתי הקבוצות – מעל 905 אבל לפוספומיצין היה מספר יותר גבוה של שיעורי ארדיקציה – 55% מול 47% בהתאמה.
לקומבינציה של פוספומיצין עם אנטביוטיקה מסוג ביטא לקטם יש תוצאות טובות בארדיקציה של פסואודומונס עמיד לטיפול כולל זנים שעמידים לקרבפנמים.
במחקר קוהורט גדול של 116 חולים (101 מבוגרים ו-15 ילדים) עם זיהומים קשים משנית לחיידקים עם עמידות נרחבת, נמצא רזולוציה קלינית של 77 תחת טיפול בקומבינציות אנטביוטיות הכולל פוספומיצין. 105 חולים עם זיהומים בעצם/מפרק ו-דלקת בשתן – היו בעלי אחוז הריפוי הכי גבוה תחת התרופה (83% ו- 100%, בהתאמה). הקומבינציות עם פוספומיצין היו יעילות בעיקר נגד פסאודומונס ארגינוזה עמיד עם 87.5% יעילותקלינית.
פרופיל בטיחות וסבילות
תופעת הלוואי הכי שכיחה בטיפול בפוספומיצין IV – היפוקלמיה והיפרנתרמיה. המכניזם קשור לעלייה בהפרשה של אשלגן בכליות על ידי הטובול הדיסטלי.
יש הסוברים גם, כי הסיבה להיפוקלמיההינו עירוי מהיר מדי של התרופות (30 עד 60 דקות) ויש ירידה באירועי היפוקלמיה כאשר היא ניתנת בטווח של 4 שעות. במחקר ZEUS נצפתה היפוקלמיה ב- 30.6% מהחולים כאשר נתנו את העירוי בטווח של 60 דקות בלבד.
גרם של פוספומיצין IV מכיל 330 מ”ג של סודיום ולכן יש לנטר חולים עם היסטוריה של אי ספיקת לב, יתר ל”ד, ואי ספיקה כבדית – תחת טיפול בתרופה זו מחשש להיפרנתרמיה. תופעות לוואי פחות שכיחות כוללות כאב באזור ההזרקה – 4%, אי ספיקת לב–החמרה– 3%, יתר ל”ד 3%, ועלייה באמינוטרנספרזות 1%.
מסקנה
פוספומיצין הינה אנטיביוטיקה ותיקה שמעוררת התעניינות מחודשת בטיפול בבקטריות עם עמידות רחבת טווח (MDR). מגנון הפעולה היחודי שלה, הפעילות הבקטריוצידית רחבת הטווח שלה, הזמינות במתן IV וגם במתן פומי ופרופיל תופעות הלוואי הנמוך – כל אלו תורמים לשקול בחיוב שימוש בה. במחקרים נצפתה עמידות לפוספומיצין כמונותרפיה, ולכן יש לשקול שילוב של התרופות ביחוד עם בטא-לאקטמים אשר לגביהם נצפתה סינרגיה IN VITRO.
נתון מעודד הוא שלמרות שימוש פעיל ב–50 שנה האחרונות באירופה ואסיה , לפוספומיצין עדיין יש אפקט יעיל נגד רוב החיידקים – גרם חיובי וגרם שלילי.
זמינות פוספומיצין IV בארה”ב מביא אופציה טיפולית נוספת בתחום האנטיביוטיקה – עליית האפוקסיד וטיפול בבקטריות עם עמידות נרחבת ( MDR).



